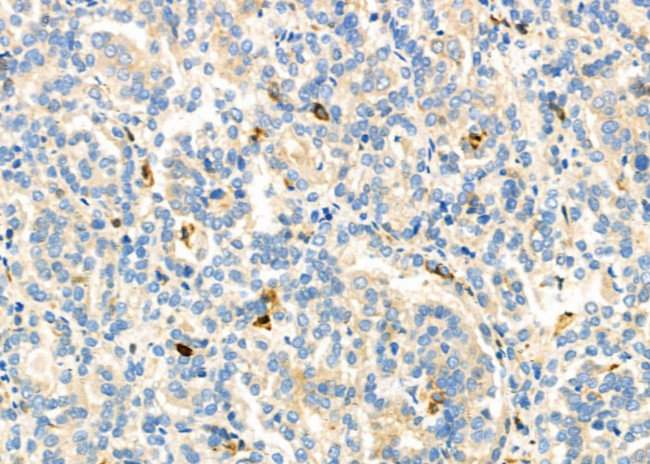
CD18 Antibody in Immunohistochemistry (Paraffin) (IHC (P))

Search
Invitrogen
CD18 Polyclonal Antibody
{{$productOrderCtrl.translations['antibody.pdp.commerceCard.promotion.promotions']}}
{{$productOrderCtrl.translations['antibody.pdp.commerceCard.promotion.viewpromo']}}
{{$productOrderCtrl.translations['antibody.pdp.commerceCard.promotion.promocode']}}: {{promo.promoCode}} {{promo.promoTitle}} {{promo.promoDescription}}. {{$productOrderCtrl.translations['antibody.pdp.commerceCard.promotion.learnmore']}}
图: 1 / 2
CD18 Antibody (PA5-115440) in IHC (P)


Please note: We are reviewing Western blot images included in the antibody testing data in our catalog, including those provided by third parties. Unless expressly labeled or annotated as “raw-unedited”, Western blot images included in the antibody testing data in our catalog may have been edited, optimized or otherwise adjusted for presentation.
产品信息
PA5-115440
种属反应
宿主/亚型
分类
类型
抗原
偶联物
形式
浓度
规格
纯化类型
保存液
内含物
保存条件
运输条件
RRID
产品详细信息
Antibody detects endogenous levels of total ITGB2/CD18.
靶标信息
CD18, also known as the integrin beta 2 subunit, is a 90-95 kDa type I transmembrane protein expressed on all leukocytes. It heterodimerizes with the alpha chains of CD11a, CD11b, CD11c, and CD11d to form various leukocyte (beta2) integrins, which are crucial for cellular adhesion and signaling. The CD18/CD11a complex, known as lymphocyte function-associated antigen-1 (LFA-1), plays a significant role in cellular adhesion and inflammatory reactions. CD18 also forms heterodimers with CD11b (Mac-1, CR3), CD11c, and CD11d, contributing to the processes of cell adhesion and cell-surface mediated signaling. These integrins are essential for proper leukocyte migration and mediating intercellular contacts. The absence of CD18 leads to leukocyte adhesion deficiency type I (LAD1), a condition characterized by impaired leukocyte migration. Severe reduction in CD18 expression can result in the development of a psoriasiform skin disease. CD18 is also a target of Mannheimia (Pasteurella) haemolytica leukotoxin, which can mediate leukotoxin-induced cytolysis. Defects in the CD18 gene are the cause of LAD1, and two transcript variants encoding the CD18 protein have been identified. The integrin-mediated responses are often a composite of the functions of its individual subunits, highlighting the importance of CD18 in immune function and disease.
仅用于科研。不用于诊断过程。未经明确授权不得转售。
篇参考文献 (0)
生物信息学
蛋白别名: CD18; CD18 leukocyte adhesion molecule; Cell surface adhesion glycoproteins LFA-1/CR3/p150,95 subunit beta; Complement receptor C3 subunit beta; Integrin beta-2; integrin, beta 2 (antigen CD18 (p95), lymphocyte function-associated antigen 1; integrin, beta 2 (antigen CD18 (p95), lymphocyte function-associated antigen 1; macrophage antigen 1 (mac-1) beta subunit); lymphocyte function associated antigen 1; Mac-1 beta; macrophage antigen 1 (mac-1) beta subunit); macrophage antigen-1 beta
基因别名: 2E6; AI528527; CD18; ITGB2; LAD; LCAMB; Lfa1; MF17; MFI7
UniProt ID: (Mouse) P11835
Entrez Gene ID: (Rat) 309684, (Mouse) 16414